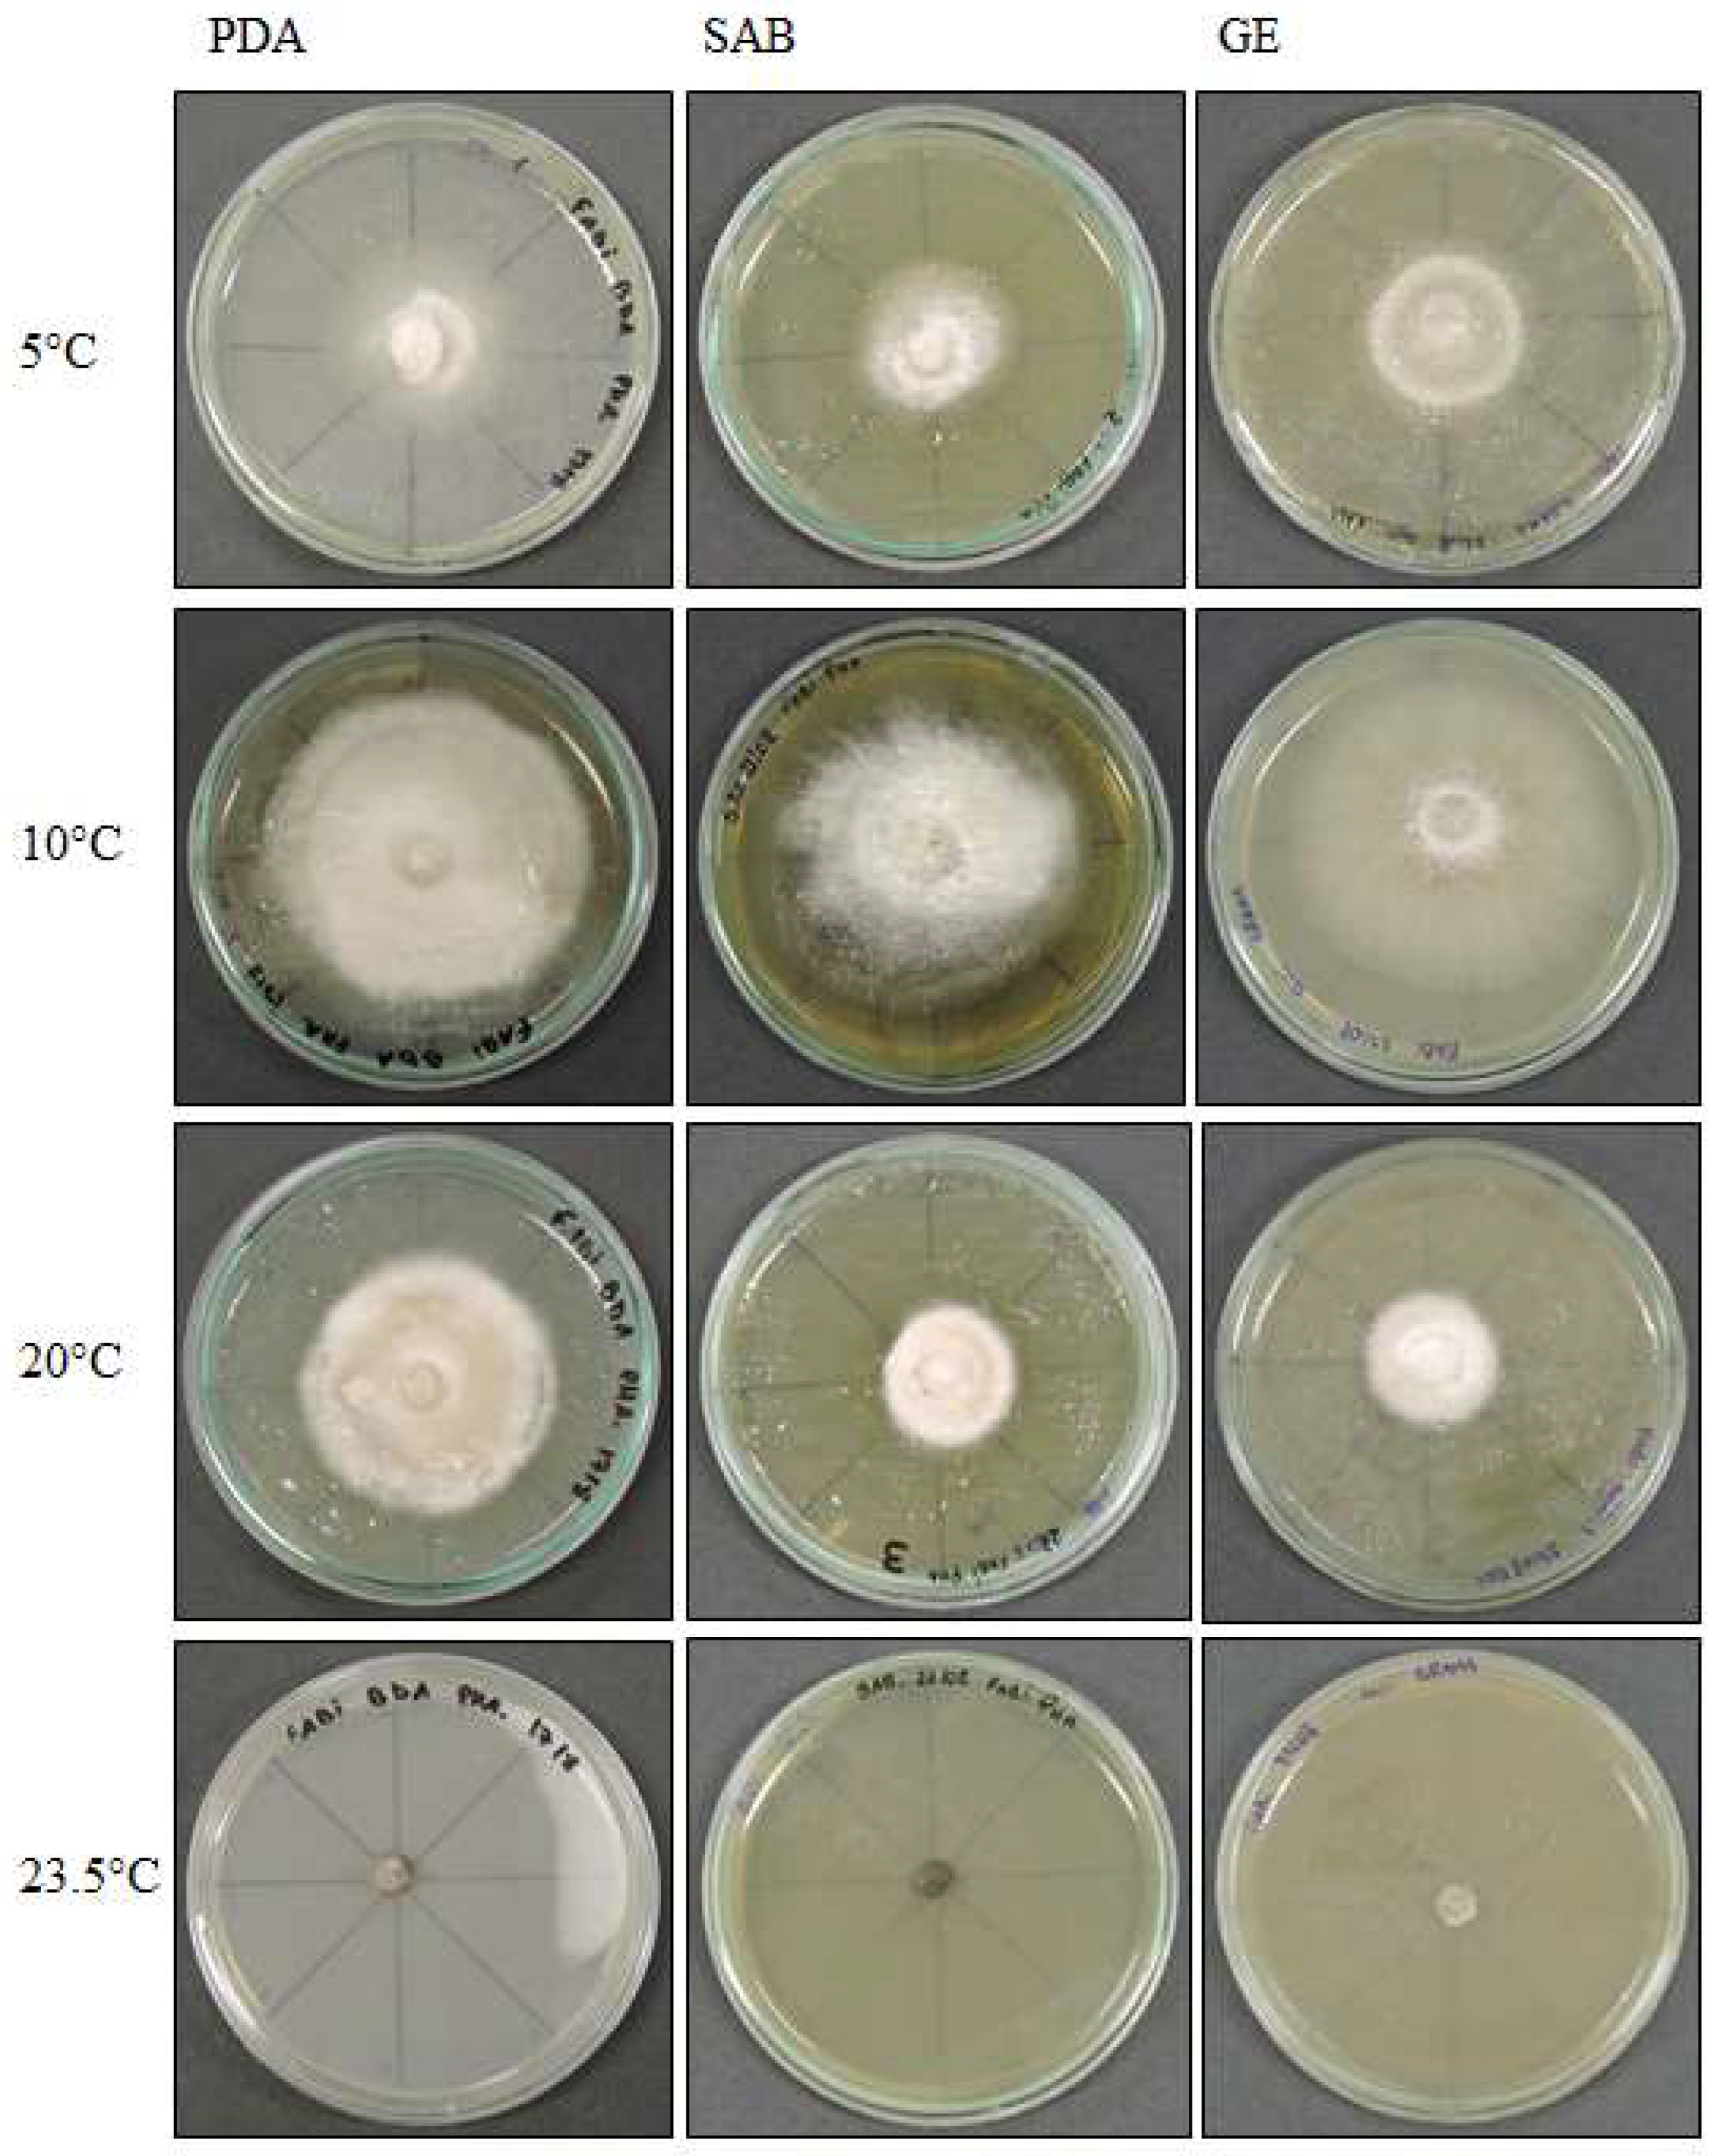
Life 12 01501 g003 Life 12 01501 g003

Impact of the Temperature in Endophytic Ascomycota Isolated from Antarctic Hair-Grass
Abstract
1. Introduction
2. Materials and Methods
2.1. Study Area
2.2. Plant Material and Isolation of the Fungi
2.3. Morphology
2.4. Molecular Analysis
Molecular Identification Analysis
2.5. Growth Experiments
3. Results
3.1. Macro- and Micro-Morphological Analyses
3.1.1. Pyrenophora cf. chaetomioides (UNIPAMPA 004)
3.1.2. Septoriella elongata (UNIPAMPA 005)
3.1.3. Neoascochyta paspali (UNIPAMPA 006)
3.1.4. Alternaria sp. (UNIPAMPA 007)
3.2. Phylogenetic Analysis
3.3. Effect of Temperature on Growth
3.3.1. Pyrenophora cf. chaetomioides
3.3.2. Septoriella elongata
3.3.3. Alternaria sp.
4. Discussion
5. Conclusions
Author Contributions
Funding
Acknowledgments
Conflicts of Interest
References
- Schellmann, K.; Kozel, S. A conquista da antártica: Signos e representações. Rev. Discente Expressões Geográficas 2005, 1, 15–26. [Google Scholar]
- Onofri, S.; Zucconi, L.; Tosi, S. Continental Antarctic Fungi; IHW Verlag: Eching, Germany, 2007. [Google Scholar]
- de Albuquerque, M.P.; Victoria, F.D.C.; Schünemann, A.L.; Putzke, J.; Gunski, R.J.; Seibert, S.; Petry, M.V.; Pereira, A.B. Plant Composition of Skuas Nests at Hennequin Point, King George Island, Antarctica. Am. J. Plant Sci. 2012, 3, 688–692. [Google Scholar] [CrossRef][Green Version]
- Putzke, J.; Pereira, A.B. Phaeosphaeria deschampsii (Ascomycota): A new parasite species of Deschampsia antarctica (Poaceae) described to Antarctica. An. Acad. Bras. Ciências 2016, 88, 1967–1969. [Google Scholar] [CrossRef] [PubMed]
- Hoshino, T.; Tojo, M.C.B.; Kanda, H. Ecological impact of phytopatogenic fungi in Antarctic terrestrial flora. Folia Fac. Sci. Nat. Univ. Masarikyanae Brun. Geogr. 2001, 25, 95–102. [Google Scholar]
- Victoria, F.C.; Pereira, A.B.; Costa, D.P. Composition and distribution of moss formations in the ice-free areas adjoining the Arctowski region, Admiralty Bay, King George Island, Antarctica. Iheringia 2009, 64, 81–91. [Google Scholar]
- Casanova-Katny, M.A.; Cavieres, L.A. Antarctic moss carpets facilitate growth of Deschampsia antarctica but not its survival. Polar Biol. 2012, 35, 1869–1878. [Google Scholar] [CrossRef]
- Barrientos-Díaz, L.; Gidekel, M.; Gutiérrez-Moraga, A. Characterization of rhizospheric bacteria isolated from Deschampsia antarctica Desv. World J. Microbiol. Biotechnol. 2008, 24, 2289–2296. [Google Scholar] [CrossRef]
- Gielwanowska, I.; Szczuka, E. New ultrastructural features of organelles in leaf cells of Deschampsia antarctica Desv. Polar Biol. 2005, 28, 951–955. [Google Scholar] [CrossRef]
- Bravo, L.A.; Griffith, M. Characterization of antifreeze activity in Antarctic plants. J. Exp. Bot. 2004, 56, 1189–1196. [Google Scholar] [CrossRef]
- Bridge, P.D.; Spooner, B.M. Non-lichenized Antarctic fungi: Transiente visitors or members of a cryptic ecosystem? Fungal Ecol. 2012, 5, 381–394. [Google Scholar] [CrossRef]
- Upson, R.; Newsham, K.K.; Read, D.J. Root-fungal associations of Colobanthus quitensis and Deschampsia antarctica in the maritime and sub-Antarctic. Arct. Antarct. Alp. Res. 2008, 40, 592–599. [Google Scholar] [CrossRef]
- Collado, J.; Platas, G.; Peláez, F. Fungal endophytes in leaves, twigs and bark of Quercus ilex from Central Spain. Nova Hedwigia 1996, 63, 347–360. [Google Scholar]
- Rosa, L.H.; Vaz, A.B.M.; Caligiorne, R.B.; Campolina, S.; Rosa, C.A. Endophytic fungi associated with the Antarctic grass Deschampsia antarctica Desv. (Poaceae). Polar Biol. 2009, 32, 161–167. [Google Scholar] [CrossRef]
- Duddington, C.L.; Wyborn, C.H.E.; Smith, R.I.L. Predacious Fungi from the Antarctic. Br. Antarct. Surv. Bull. 1973, 35, 87–90. [Google Scholar]
- Kernaghan, G.; Patriquin, G. Host associations between fungal root endophytes and boreal trees. Microb. Ecol. 2011, 62, 460–473. [Google Scholar] [CrossRef]
- Ruisi, S.; Barreca, D.; Selbmann, L.; Zucconi, L.; Onofri, S. Fungi in Antarctica. Rev. Environ. Sci. Bio/Technol. 2007, 6, 127–141. [Google Scholar] [CrossRef]
- Huang, Y.; Wang, J.; Li, G.; Zheng, Z.; Su, W. Antitumor and antifungal activities in endophytic fungi isolated from pharmaceutical plants Taxus mairei, Cephalataxus fortune and Torreya grandis. FEMS Immunol. Med. Microbiol. 2001, 31, 163–167. [Google Scholar] [CrossRef]
- Rodriguez, R.J.; White, J.F., Jr.; Arnold, A.E.; Redman, R.S. Fungal endophytes: Diversity and functional roles. New Phytol. 2009, 182, 314–330. [Google Scholar] [CrossRef]
- Sun, X.; Guo, L.-D.; Hyde, K.D. Community composition of endophytic fungi in Acer truncatum and their role in decomposition. Fungal Divers. 2011, 47, 85–95. [Google Scholar] [CrossRef]
- Esponda, C.M.G.; Coria, N.R.; Montalti, D. Breeding birds at Halfmoon Island, South Shetland Islands, Antarctica. Mar. Ornithol. 2000, 28, 59–62. [Google Scholar]
- Castellani, A. Maintenance and cultivation of common pathogenicfungi in distilled water. J. Trop Med. Hygien. 1967, 42, 181–184. [Google Scholar]
- OACC. The Online Auction Colour Chart: The New Language of Colour for Buyers and Sellers; OACC: Palo Alto, CA, USA, 2004; 12p. [Google Scholar]
- Borba, R.S.; Enimar Loeck, A.; de Magalhães Bandeira, J.; Leivas Moraes, C.; Centenaro, E.D. Crescimento do fungo simbionte de formigas cortadeiras do gênero Acromyrmex em meios de cultura com diferentes extratos. Ciência Rural. 2016, 36, 3. [Google Scholar] [CrossRef]
- Vilgalys, R.; Hester, M. Rapid genetic identification and mapping of enzymatically amplified ribosomal DNA from several Cryptococcus species. J. Bacteriol. 1990, 172, 4238–4246. [Google Scholar] [CrossRef]
- White, T.J.; Bruns, T.D.; Lee, S.B. AmpliWcation and direct sequencing of fungal ribosomal RNA genes for phylogenetics. In PCR Protocols: A Guide to Methods and Applications; Academic Press: San Diego, CA, USA, 1990; Volume 18, pp. 315–322. [Google Scholar]
- Hall, T.A. BioEdit: A User-Friendly Biological Sequence Alignment Editor and Analysis Program for Windows 95/98/NT. Nucleic Acids Symp. Ser. 1999, 41, 95–98. [Google Scholar]
- Altuschul, S.F.; Madden, T.L.; Schaver, A.A.; Zhang, J.H.; Zhang, Z.; Miller, W.; Lipman, D.J. Gapped BLAST and PSI-BLAST: A new generation of protein database search programs. Nucleic Acids Res. 1997, 25, 3389–3402. [Google Scholar] [CrossRef]
- Tamura, K.; Stecher, G.; Peterson, D.; Filipski, A.; Kumar, S. MEGA6: Molecular evolutionary genetics analysis version 6.0. Mol. Biol. Evol. 2013, 30, 2725–2729. [Google Scholar] [CrossRef]
- Drummond, A.J.; Suchard, M.A.; Xie, D.; Rambaut, A. Bayesian phylogenetics with BEAUti and the BEAST 1.7. Mol. Biol. Evol. 2012, 29, 1969–1973. [Google Scholar] [CrossRef] [PubMed]
- Rambaut, A.; Suchard, M.A.; Xie, D.; Drummond, A.J. Tracer v1.6. 2014. Available online: http://beast.bio.ed.ac.uk/Tracer (accessed on 31 July 2017).
- Zhang, T.; Zhang, Y.-Q.; Liu, H.-Y.; Wei, Y.-Z.; Li, H.-L.; Su, J.; Zhao, L.-X.; Yu, L.-Y. Diversity and cold adaptation of culturable endophytic fungi from bryophytes in the Fildes Region, King George Island, maritime Antarctica. FEMS Microbiol. Lett. 2013, 341, 52–61. [Google Scholar] [CrossRef] [PubMed]
- Chambers, J.M.; Freeny, A.; Heiberger, R.M. Analysis of variance; designed experiments. In Statistical Models; Routledge: London, UK, 1992; pp. 145–193. [Google Scholar]
- Royston, J.P. Algorithm AS 181: The W test for Normality. J. R. Stat. Soc. Ser. C Appl. Stat. 1982, 31, 176. [Google Scholar] [CrossRef]
- Royston, J.P. An extension of Shapiro and Wilk’s W test for normality to large samples. J. R. Stat. Soc. Ser. C Appl. Stat. 1982, 31, 115–124. [Google Scholar] [CrossRef]
- Royston, P.J. Remark AS R94: A Remark on Algorithm as 181: The W test for normality. J. R. Stat. Soc. Ser. C Appl. Stat. 1995, 44, 547–551. [Google Scholar] [CrossRef]
- Mangiafico, S. Rcompanion: Functions to Support Extension Education Program Evaluation. R Package Version 1.10.1. 2017. Available online: https://CRAN.R-project.org/package=rcompanion (accessed on 30 May 2018).
- R Core Team. R: A Language and Environment for Statistical Computing; R Foundation for Statistical Computing: Vienna, Austria, 2017; Available online: https://www.R-project.org/ (accessed on 30 May 2018).
- Ariyawansa, H.A.; Hawksworth, D.L.; Hyde, K.D.; Jones, E.B.G.; Maharachchikumbura, S.S.N.; Manamgoda, D.S.; Thambugala, K.M.; Udayanga, D.; Camporesi, E.; Daranagama, A.; et al. Epitypification and neotypification: Guidelines with appropriate and inappropriate examples. Fungal Divers. 2014, 69, 57–91. [Google Scholar] [CrossRef]
- Li, W.J.; Bhat, D.J.; Camporesi, E.; Tian, Q.; Wijayawardene, N.N.; Dai, D.Q.; Phookamsak, R.; Chomnunti, P.; Bahkali, A.H.; Hyde, K.D. New asexual morph taxa in Phaeosphaeriaceae. Mycosphere 2015, 6, 681–708. [Google Scholar] [CrossRef]
- Aveskamp, M.M.; de Gruyter, J.; Woudenberg, J.H.C.; Verkley, G.J.M.; Crous, P.W. Highlights of the Didymellaceae: A polyphasic approach to characterise Phoma and related pleosporalean genera. Stud. Mycol. 2010, 65, 1–60. [Google Scholar] [CrossRef]
- Chen, Q.; Jiang, J.R.; Zhang, G.Z.; Cai, L.; Crous, P.W. Resolving the Phoma enigma. Stud. Mycol. 2015, 82, 137–217. [Google Scholar] [CrossRef]
- Zhang, Y.; Schoch, C.; Fournier, J.; Crous, P.; de Gruyter, J.; Woudenberg, J.; Hirayama, K.; Tanaka, K.; Pointing, S.; Spatafora, J.; et al. Multi-locus phylogeny of Pleosporales: A taxonomic, ecological and evolutionary re-evaluation. Stud. Mycol. 2009, 64, 85–102. [Google Scholar] [CrossRef]
- Aveskamp, M.M.; De Gruyter, J.; Crous, P.W. Biology and recent developments in the systematics of Phoma, a complex genus of major quarantine significance. Fungal Divers. 2008, 31, 1–18. [Google Scholar]
- Woudenberg, J.H.; Groenewald, J.Z.; Binder, M.; Crous, P.W. Alternaria redefined. Stud. Mycol. 2013, 75, 171–212. [Google Scholar] [CrossRef]
- Petrini, O. Taxonomy of endophytic fungi of aerial plant tissues. In Microbiology of the Phyllosphere; Fokkema, N.J., Van Den Huevel, J., Eds.; Cambridge University Press: Cambridge, UK, 1986. [Google Scholar]
- Higgins, K.L.; Arnold, A.E.; Miadlikowska, J.; Sarvate, S.D.; Lutzoni, F. Phylogenetic relationships, host affinity, and geographic structure of boreal and arctic endophytes from three major plant lineages. Mol. Phylogen. Evol. 2007, 42, 543–555. [Google Scholar] [CrossRef]
- Saikkonen, K.; Ahlholm, J.; Helander, M.; Lehtimäki, S.; Niemeläinen, O. Endophytic fungi in wild and cultivated grasses in Finland. Ecography 2000, 23, 360–366. [Google Scholar] [CrossRef]
- Davis, E.C.; Shaw, A.J. Biogeographic and phylogenetic patterns in diversity of liverwort-associated endophytes. Am. J. Bot. 2008, 95, 914–924. [Google Scholar] [CrossRef] [PubMed]
- Dennis, R.W.G. Fungi from South Georgia. Kew Bull. 1968, 22, 445. [Google Scholar] [CrossRef]
- Stchigel, A.M.; Calduch, M.; Mac Cormack, W.; Guarro, J. Phaeosphaeria microscopica (Karsten) O. Erikss.: First report on Deschampsia antarctica Desv. Boletín Micológico 2004, 19, 111–115. [Google Scholar] [CrossRef]
- Carson, M.L. Vulnerability of U.S. maize germ plasm to phaeosphaeria leaf spot. Plant Dis. 1999, 83, 462–464. [Google Scholar] [CrossRef]
- Ernst, M.; Mendgen, K.W.; Wirsel, S.G.R. Endophytic fungal mutualists: Seed-borne Stagonospora spp. enhance reed biomass production in axenic microcosms. Mol. Plant-Microbe Interact. 2003, 16, 580–587. [Google Scholar] [CrossRef]
- Marin-Felix, Y.; Hernández-Restrepo, M.; Iturrieta-González, I.; García, D.; Gené, J.; Groenewald, J.Z.; Cai, L.; Chen, Q.; Quaedvlieg, W.; Schumacher, R.K.; et al. Genera of phytopathogenic fungi: GOPHY 3. Stud. Mycol. 2019, 94, 1–124. [Google Scholar] [CrossRef]
- Shoemaker, R.A.; Babcock, C.E. Phaeosphaeria. Can. J. Bot. 1989, 67, 1500–1599. [Google Scholar] [CrossRef]
- Kohlmeyer, J.; Kohlmeyer, E. Marine Mycology: The Higher Fungi; Elsevier: Amsterdam, The Netherlands, 1979. [Google Scholar]
- Crous, P.W.; Groenewald, J.Z. Stagonospora pseudopaludosa. Fungal Planet. 2013. Available online: https://www.fungalplanet.org/ (accessed on 2 July 2019).
- Romberg, M.K.; Rooney-Latham, S. Stagonospora chrysopyla. Fungal Planet. 2014. Available online: https://www.fungalplanet.org/ (accessed on 3 July 2019).
- de Gruyter, J.; Aveskamp, M.M.; Woudenberg, J.H.; Verkley, G.J.; Groenewald, J.Z.; Crous, P.W. Molecular phylogeny of Phoma and allied anamorph genera: Towards a reclassification of the Phoma complex. Mycol. Res. 2009, 113, 508–519. [Google Scholar] [CrossRef]
- Pegler, D.N.; Spooner, B.M.; Smith, R.L. Higher fungi of Antarctica, the subantarctic zone and Falkland Islands. Kew Bull. 1980, 35, 499–562. [Google Scholar] [CrossRef]
- Jankowiak, R.; Bilański, P.; Paluch, J.; Kołodziej, Z. Fungi associated with dieback of Abies alba seedlings in naturally regenerating forest ecosystems. Fungal Ecol. 2016, 24, 61–69. [Google Scholar] [CrossRef]
- Cervelatti, E.; Paccola-Meirelles, L.D.; Fernandes, F.; Oliveira, A.C. Adequação das condições de germinação e crescimento de Phyllostictasp (fpPhaeosphaeria maydis) e avaliação da produção de exoenzimasenvolvidas na penetração do patógeno na planta. In EmbrapaMilho e Sorgo-Artigo em Anais de Congress (ALICE), Proceedings of the Congresso Nacional de Milho e Sorgo, Recife, Brazil, 1998; ABMS: Recife, Brazil, 1998; p. 22. [Google Scholar]
- Boerema, G.H. (Ed.) Phoma Identification Manual: Differentiation of Specific and Infra-Specific Taxa in Culture; CABI: Wallingford, UK, 2004. [Google Scholar]
- Lin, Z.; Que, Y.; Deng, Z.H.; Xu, S.Q.; Rao, G.P.; Zhang, M.Q. First report of Phoma sp. causing twisting and curling of crown leaves of sugarcane in mainland of China. Plant Dis. 2014, 98, 850. [Google Scholar] [CrossRef]
- Lin, Z.; Wei, J.; Zhang, M.; Xu, S.; Guo, Q.; Wang, X.; Wang, J.; Chen, B.; Que, Y.; Deng, Z.; et al. Identification and characterization of a new fungal pathogen causing twisted leaf disease of sugarcane in China. Plant Dis. 2015, 99, 325–332. [Google Scholar] [CrossRef]
- Zhang, T.; Yao, Y.-F. Endophytic fungal communities associated with vascular plants in the high arctic zone are highly diverse and host-plant specific. PLoS ONE 2015, 10, e0130051. [Google Scholar] [CrossRef]
- Vishniac, H.S. Biodiversity of yeasts and filamentous microfungi in terrestrial Antarctic ecosystems. Biodivers. Conserv. 1996, 5, 1365–1378. [Google Scholar] [CrossRef]
- Soliai, M.M.; Meyer, S.E.; Udall, J.A.; Elzinga, D.E.; Hermansen, R.A.; Bodily, P.M.; Hart, A.A.; Coleman, C.E. De novo Genome Assembly of the Fungal Plant Pathogen Pyrenophora semeniperda. PLoS ONE 2014, 9, e87045. [Google Scholar] [CrossRef]
- Cegiełko, M.; Kiecana, I.; Kachlicki, P.; Wakuliski, W. Pathogenicity of Drechsleraavenae for leaves of selected oat gen-otypes and ist ability to produce anthraquinone compounds. Acta Sci. Pol. Hortorum Cultus 2011, 10, 11–22. [Google Scholar]
- Neergard, P. Seed Pathology; The Macmillan: London, UK, 1979. [Google Scholar]
- Benslimane, H.; Aouali, S.; Khalfi, A.; Ali, S.; Bouznad, Z. In Vitro Morphological Characteristics of Pyrenophora tritici-repentis Isolates from Several Algerian Agro-Ecological Zones. Plant Pathol. J. 2017, 33, 109–117. [Google Scholar] [CrossRef]
- Arnold, A.E.; Lutzoni, F. Diversity and host range of foliar fungal endophytes: Are tropical leaves biodiversity hotspots? Ecology 2007, 88, 541–549. [Google Scholar] [CrossRef]
- Petrini, O.; Petrini, L. Xylariaceous fungi as endophytes. Sydowia Ann. Mycol. 1985, 38, 216–234. [Google Scholar]
- Holm, L.; Holm, K. The genus Pleospora s. 1. from Svalbard. Sydowia 1993, 45, 167–187. [Google Scholar]
- El-Alwany, A.M. Plant Pathogenic Alternaria Species in Libya. Open Access Libr. J. 2015, 2, 1–8. [Google Scholar] [CrossRef]
- Grum-Grzhimaylo, A.A.; Georgieva, M.; Bondarenko, S.A.; Debets, A.J.M.; Bilanenko, E.N. On the diversity of fungi from soda soils. Fungal Divers. 2015, 76, 27–74. [Google Scholar] [CrossRef]
- Linhares, A.I.; Matsumura, A.; Luz, V. Avaliação da amplitude de açãoantagonística de microrganismosepífitas do trigosobre o crescimento radial de Drechsleratritici-repentis. Curr. Agric. Sci. Technol. 1995, 1, 1–8. [Google Scholar] [CrossRef]
- Khouri, C.R. Efeito de extratos de gramíneasforrageiras no crescimento do fungosimbionte de Acromyrmex (Moellerius) balzani (Hymenoptera, Formicidae). Simpósio Mirmecologia 2003, 16, 483–485. [Google Scholar]
- Reis, E.M. Patologia de sementes de cereais de inverno. In EmbrapaTrigo-Folderes/Folhetos/Cartilhas (INFOTECA-E); CNDA: São Paulo, Brazil, 1998. [Google Scholar]
- Campbell, M.; Medd, R.; Brown, J. Growth and sporulation of Pyrenophora semeniperda in vitro: Effects of culture media, temperature and pH. Mycol. Res. 1996, 100, 311–317. [Google Scholar] [CrossRef]
- Tosi, S.; Casado, B.; Gerdol, R.; Caretta, G. Fungi isolated from antarctic mosses. Polar Biol. 2002, 25, 262–268. [Google Scholar] [CrossRef]
- Newsham, K.K.; Hopkins, D.; Carvalhais, L.C.; Fretwell, P.T.; Rushton, S.P.; O’Donnell, A.G.; Dennis, P.G. Relationship between soil fungal diversity and temperature in the maritime Antarctic. Nat. Clim. Chang. 2016, 6, 182–186. [Google Scholar] [CrossRef]

| Treatments | Septoriella elongata | Pyrenophora cf. chaetomioides |
|---|---|---|
| 5 °C | 1.111 c | 0.537 c |
| 10 °C | 2.295 a | 0.989 b |
| 20 °C | 1.642 b | 2.361 a |
| 23.5 °C | - | 0.704 bc |
Publisher’s Note: MDPI stays neutral with regard to jurisdictional claims in published maps and institutional affiliations. |
© 2022 by the authors. Licensee MDPI, Basel, Switzerland. This article is an open access article distributed under the terms and conditions of the Creative Commons Attribution (CC BY) license (https://creativecommons.org/licenses/by/4.0/).
Share and Cite
Lucini, F.; de Andrade, G.A.K.; Victoria, F.d.C.; de Albuquerque, M.P. Impact of the Temperature in Endophytic Ascomycota Isolated from Antarctic Hair-Grass. Life 2022, 12, 1501. https://doi.org/10.3390/life12101501
Lucini F, de Andrade GAK, Victoria FdC, de Albuquerque MP. Impact of the Temperature in Endophytic Ascomycota Isolated from Antarctic Hair-Grass. Life. 2022; 12(10):1501. https://doi.org/10.3390/life12101501
Chicago/Turabian StyleLucini, Fabíola, Guilherme Afonso Kessler de Andrade, Filipe de Carvalho Victoria, and Margéli Pereira de Albuquerque. 2022. "Impact of the Temperature in Endophytic Ascomycota Isolated from Antarctic Hair-Grass" Life 12, no. 10: 1501. https://doi.org/10.3390/life12101501
APA StyleLucini, F., de Andrade, G. A. K., Victoria, F. d. C., & de Albuquerque, M. P. (2022). Impact of the Temperature in Endophytic Ascomycota Isolated from Antarctic Hair-Grass. Life, 12(10), 1501. https://doi.org/10.3390/life12101501

